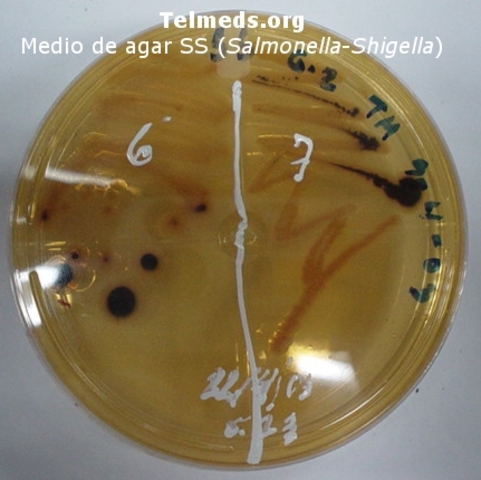
Introducción de los indicadores de PH en los medios de cultivo

-
Zacharias Janssen
-
Robert Hooke
-
Marcello Malpighi
-
Antony Leeuwenhoek descubre los microorganismos ("animálculos")
-
Antonie Van Leeuwenhoek
-
Primera vacuna contra la viruela de Edward Jenner
-
Pasteur rechaza que los animales crecian de la materia orgánica
-
-
Primera prueba de la teoría microbiana por Robert Kooch
-
Este método fue un aliciente para que Gram comenzara sus experimentos con la tinción de bacterias. Paul Ehrlich
-
-
Christian Gram
-
Louis Pasteur
-
R.J. Petri
-
Dmitri Iosifovich Ivanovski
-
Wurtz
-
Martinus Beijerinck
-
Walter Reed
-
Paul Ehrlich
-
Alexandre Fleming
-
Chain y Florey
-
W. Gilbert & F. Sanger
-
Kary Mullis
-
TIGR institute
A list shows items. A timeline shows sequence.
Use Timetoast to make dates, milestones, and turning points easier to understand in a clear visual format. Timetoast is a timeline maker for work, school, research, and stories.